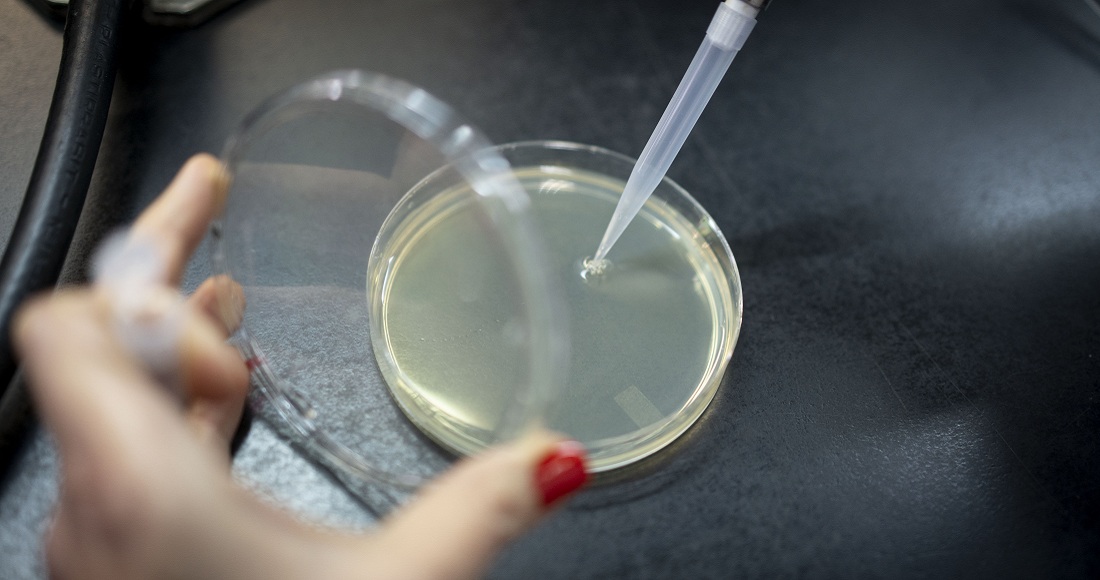
Aprendizaje de bacterias

En este estudio, realizado mediante el procedimiento denominado metaanálisis, se concluye que mascar chicle, algo tan barato, tan a mano y tan bien tolerado por nuestro organismo, es un modo efectivo de reducir el estrés y la ansiedad.
Estados Unidos, 5 de mayo (The Conversation).-- Quien no se estrese que levante la mano. Y bien está que nos estresemos algún día y de modo puntual, pero con frecuencia sentimos que nos estresamos incluso varias veces en el mismo día.
En este sentido, y según la Confederación Europea de Sindicatos, el 60 por ciento de los días que se pierden en el trabajo se relacionan con el estrés y los riesgos psicosociales. Es más, consideran que el estrés es una epidemia.
Y puesto que hay evidencias que apuntan a que el estrés puede contribuir al desarrollo de trastornos mentales como la ansiedad y la depresión, si no podemos controlar las situaciones que nos estresan, ¿cómo podemos al menos reducir el estrés que estas situaciones nos generan? ¿Sirve de algo, por ejemplo, mascar chicle?
Un estudio reciente ha recopilado y analizado toda una serie de trabajos que se han llevado a cabo para demostrar si mascar chicle ayuda o no a reducir el estrés.
@fjesteban (@ujaen) nos cuenta sus conclusiones:
https://t.co/gjsbbVkt5h— The Conversation ES (@Conversation_E) March 4, 2023
PUES A MASCAR CHICLE
Un estudio reciente ha recopilado y analizado toda una serie de trabajos que se han llevado a cabo para demostrar si mascar chicle ayuda o no a reducir el estrés.
En este estudio, realizado mediante el procedimiento denominado metaanálisis, se concluye que mascar chicle, algo tan barato, tan a mano y tan bien tolerado por nuestro organismo, es un modo efectivo de reducir el estrés y la ansiedad. No obstante, también se indica que serían necesarios más estudios para su confirmación inequívoca.
¿Y cómo surte este efecto? Entre los trabajos analizados los hay que indican que una de las zonas del cerebro implicadas es la corteza prefrontal que, actuando sobre el eje hipotálamo-hipófisis-adrenal y el sistema nervioso autónomo, participa en el control de funciones cognitivas tales como la atención y la inhibición de los impulsos.

En ese sentido, también hay estudios que indican que el propio hecho de mascar chicle y su sabor influyen sobre los niveles de cortisol, la hormona del estrés, producida por las glándulas adrenales. Es más, se podría considerar como un indicador de emociones positivas de ayuda en situaciones estresantes.
MASCAR CHILE Y COMER MENOS
Pero eso no es todo. Mascar chicle también reduce el apetito y hace que picoteemos menos, algo interesante a tener en cuenta si queremos comer poco. Concretamente, lo estudios indican que con 45 minutos mascando chicle podemos conseguirlo.
Además, también disminuyó la sensación de apetito en un grupo de personas que mascaron chicle sin azúcar después de 12 horas de ayuno. En ellas se detectó el aumento de una proteína relacionada con el glucagón, la GLP-1, que normalmente aumenta después de comer y que se propone como un factor de saciedad.
Sin embargo, es interesante destacar que otro estudio indica que mascar chicles de menta reduce las ganas de comer fruta, y esto, sin duda, afecta a la calidad de los alimentos que ingerimos.

Curiosamente, en el caso de quienes se han sometido a intervenciones quirúrgicas abdominales, el efecto de mascar chicle es el contrario: disminuye el tiempo que tarda en volver la sensación de hambre. Por eso se plantea usarlo como tratamiento postoperatorio no farmacológico que ayude a recuperar el apetito de estas personas cuanto antes.
OTROS BENEFICIOS DE MASCAR CHICLE
Aun con evidencias no del todo concluyentes, parece que los chicles sin azúcar, y concretamente aquellos con xylitol como edulcorante, ejercen un efecto complementario al cepillado de dientes que reduce la inflamación de las encías.
Y, en relación con los efectos secundarios de la quimioterapia en pacientes pediátricos, como las úlceras que pueden aparecer en la boca (mucositis oral), hay trabajos que indican que mascar chicle puede ser efectivo para reducir la mucositis moderada o leve.

Para terminar con otro ejemplo de los posibles beneficios de masticar chicle, recientemente se ha detectado que mascar chicle antes de una intervención quirúrgica disminuye la sensación de sed y se relaciona tanto con una menor incidencia de náuseas como de molestias en la garganta, ronquera y ganas de ir al baño después de la operación, además de un menor tiempo de hospitalización.
Eso sí, todas y todos tranquilos porque parece ser que, frente al estereotipo popular, tanto mujeres como hombres somos igualmente multitarea y podemos andar y mascar chicle a la vez.